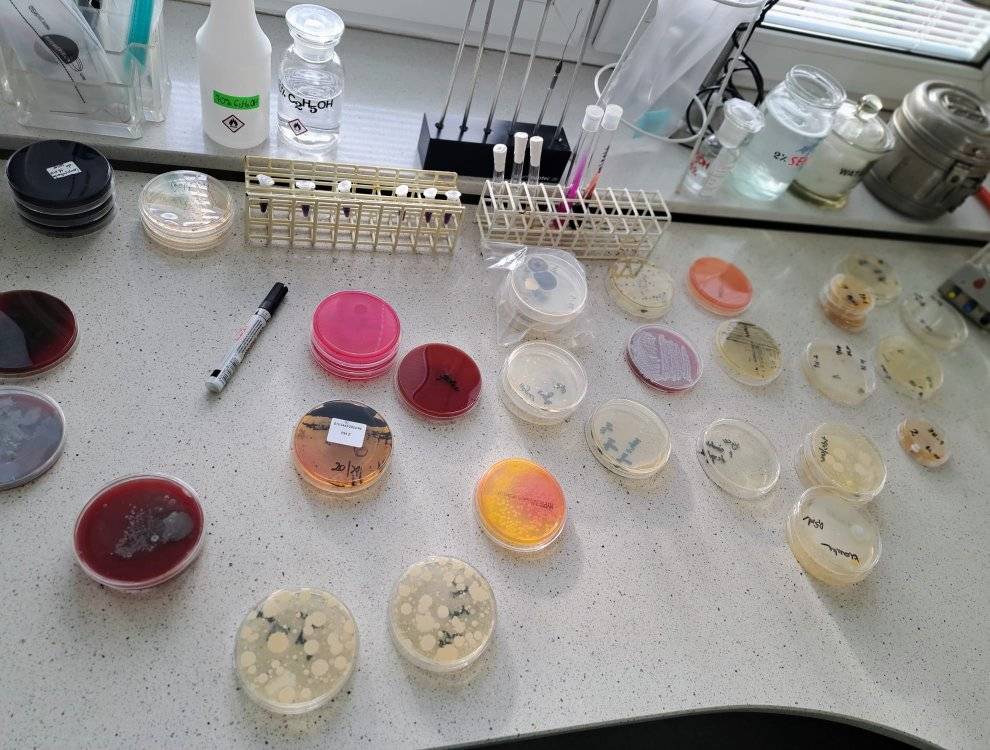

Gastronomik ponownie na zajęciach w Wojewódzkiej Stacji Sanitarno-Epidemiologicznej w Poznaniu.
Tematem przewodnim dzisiejszego spotkania było bezpieczeństwo zdrowotne i higiena pracy, czyli wiedza niezbędna w zawodzie kucharza. Widok bakterii pod mikroskopem i to tych znalezionych na brudnych dłoniach czy telefonie, zdecydowanie daje do myślenia. Świetne spotkanie! Bardzo dziękujemy!